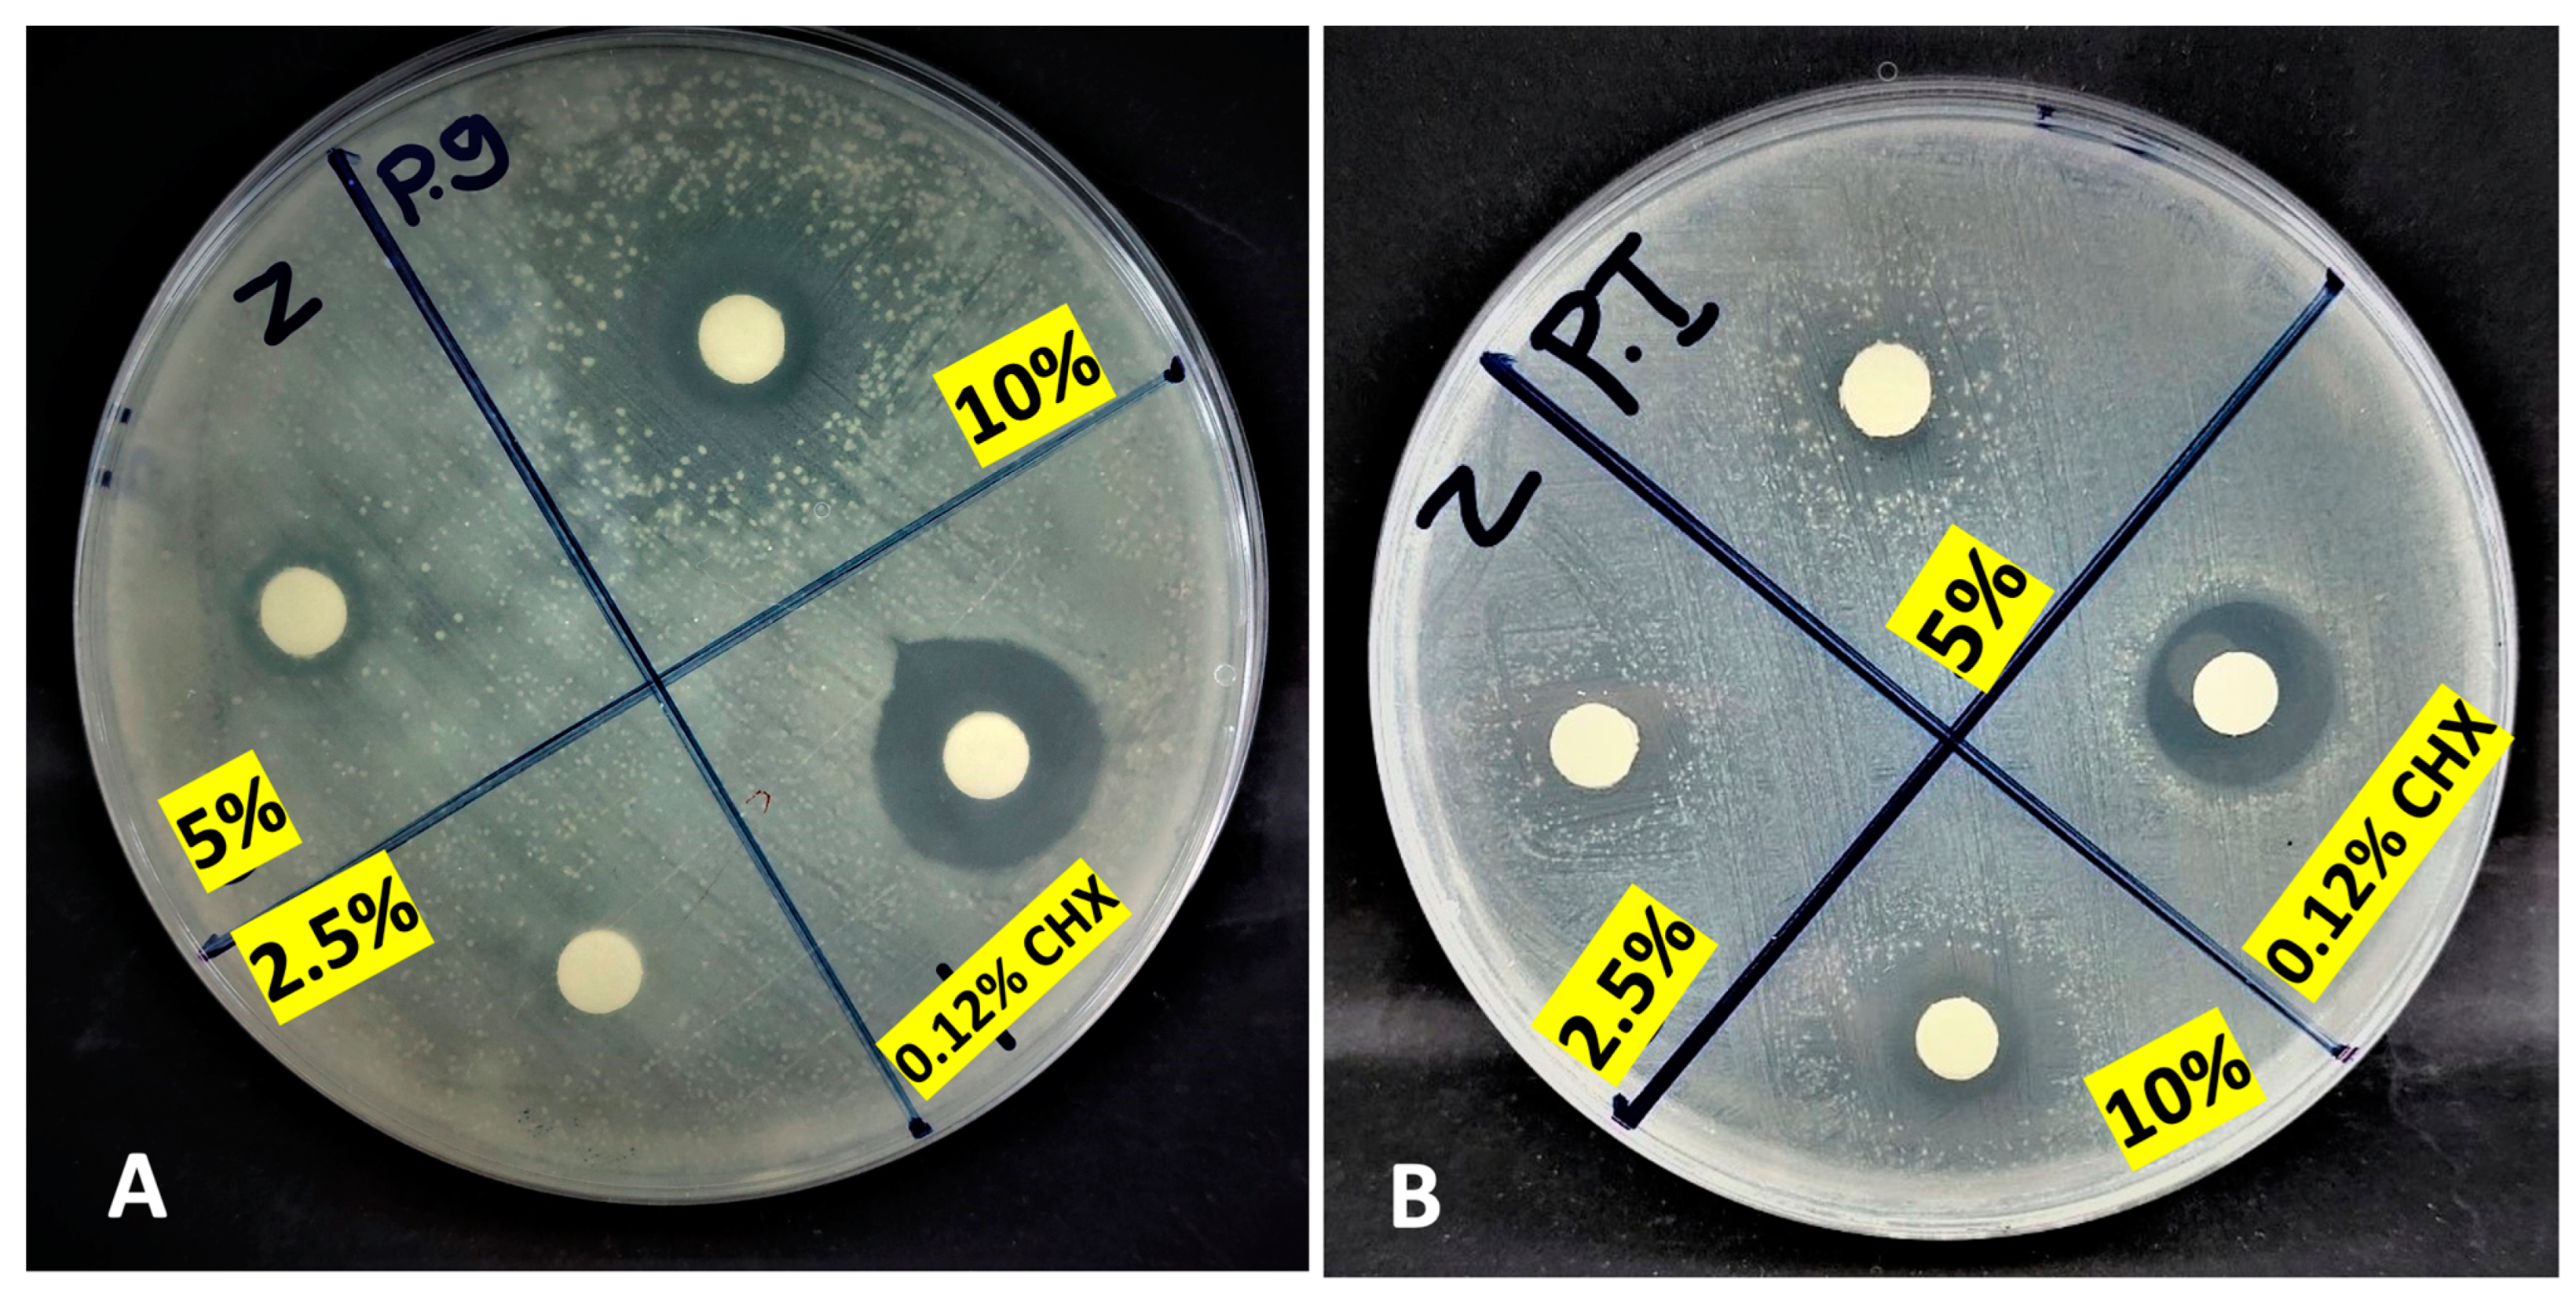
Applsci 13 07996 g002

Extraction of Cuminum cyminum and Foeniculum vulgare Essential Oils and Their Antibacterial and Antibiofilm Activity against Clinically Isolated Porphyromonas gingivalis and Prevotella intermedia: An In Vitro Study
Abstract
1. Introduction
2. Materials and Methods
2.1. Collection of the Plant’s Seeds
2.2. Essential Oil Extraction
2.3. Gas Chromatography–Mass Spectrometry (GC-MS)
2.4. Subgingival Plaque Sample Collection and Bacterial Growth Conditions
2.5. Reviving P. gingivalis and Isolation of P. intermedia
2.6. Antibacterial Assays
2.7. Minimum Inhibitory and Bactericidal Concentrations
2.8. Antibiofilm Assays
2.9. Statistical Analysis
3. Results
3.1. Bacterial Strains
3.2. GC-MS of the Examined EOs
3.3. Antibacterial Assays
3.4. Minimum Inhibitory and Bactericidal Concentrations
3.5. Antibiofilm Assays
4. Discussion
5. Conclusions
Author Contributions
Funding
Institutional Review Board Statement
Informed Consent Statement
Data Availability Statement
Acknowledgments
Conflicts of Interest
References
- Könönen, E.; Gursoy, M.; Gursoy, U.K. Periodontitis: A Multifaceted Disease of Tooth-Supporting Tissues. J. Clin. Med. 2019, 8, 1135. [Google Scholar] [CrossRef]
- Hajishengallis, G.; Chavakis, T.; Lambris, J.D. Current understanding of periodontal disease pathogenesis and targets for host-modulation therapy. Periodontology 2000 2020, 84, 14–34. [Google Scholar] [CrossRef] [PubMed]
- Picolos, D.K.; Lerche-Sehm, J.; Abron, A.; Fine, J.B.; Papapanou, P.N. Infection patterns in chronic and aggressive periodontitis. J. Clin. Periodontol. 2005, 32, 1055–1061. [Google Scholar] [CrossRef] [PubMed]
- Gul, S.S.; Griffiths, G.S.; Stafford, G.P.; Al-Zubidi, M.I.; Rawlinson, A.; Douglas, C.W. Investigation of a novel predictive biomarker profile for the outcome of periodontal treatment. J. Periodontol. 2017, 88, 1135–1144. [Google Scholar]
- Hajishengallis, G.; Darveau, R.P.; Curtis, M.A. The keystone-pathogen hypothesis. Nat. Rev. Microbiol. 2012, 10, 717–725. [Google Scholar] [CrossRef] [PubMed]
- Haffajee, A.D.; Socransky, S.S. Microbial etiological agents of destructive periodontal diseases. Periodontology 2000 1994, 5, 78–111. [Google Scholar] [CrossRef] [PubMed]
- Nakagawa, S.; Fujii, H.; Machida, Y.; Okuda, K. A longitudinal study from prepuberty to puberty of gingivitis. Correlation between the occurrence of Prevotella intermedia and sex hormones. J. Clin. Periodontol. 1994, 21, 658–665. [Google Scholar] [CrossRef] [PubMed]
- Smiley, C.J.; Tracy, S.L.; Abt, E.; Michalowicz, B.S.; John, M.T.; Gunsolley, J.; Cobb, C.M.; Rossmann, J.; Harrel, S.K.; Forrest, J.L.; et al. Systematic review and meta-analysis on the nonsurgical treatment of chronic periodontitis by means of scaling and root planing with or without adjuncts. J. Am. Dent. Assoc. 2015, 146, 508–524.e5. [Google Scholar] [CrossRef]
- Haffajee, A.D.; Dibart, S.; Kent, R.L., Jr.; Socransky, S.S. Factors associated with different responses to periodontal therapy. J. Clin. Periodontol. 1995, 22, 628–636. [Google Scholar] [CrossRef]
- Eid Abdelmagyd, H.A.; Ram Shetty, D.S.; Musa Musleh Al-Ahmari, D.M. Herbal medicine as adjunct in periodontal therapies- A review of clinical trials in past decade. J. Oral Biol. Craniofacial Res. 2019, 9, 212–217. [Google Scholar] [CrossRef]
- Atanasov, A.G.; Waltenberger, B.; Pferschy-Wenzig, E.M.; Linder, T.; Wawrosch, C.; Uhrin, P.; Temml, V.; Wang, L.; Schwaiger, S.; Heiss, E.H.; et al. Discovery and resupply of pharmacologically active plant-derived natural products: A review. Biotechnol. Adv. 2015, 33, 1582–1614. [Google Scholar] [CrossRef]
- Tanhaieian, A.; Pourgonabadi, S.; Akbari, M.; Mohammadipour, H.S. The effective and safe method for preventing and treating bacteria-induced dental diseases by herbal plants and a recombinant peptide. J. Clin. Exp. Dent. 2020, 12, e523–e532. [Google Scholar] [CrossRef]
- Lee, H.; Kim, K.; Choi, Y.; Kim, D. Emissions of Volatile Organic Compounds (VOCs) from an Open-Circuit Dry Cleaning Machine Using a Petroleum-Based Organic Solvent: Implications for Impacts on Air Quality. Atmosphere 2021, 12, 637. [Google Scholar]
- Head, N.E.; Yu, H. Cross-sectional analysis of clinical and environmental isolates of Pseudomonas aeruginosa: Biofilm formation, virulence, and genome diversity. Infect. Immun. 2004, 72, 133–144. [Google Scholar] [PubMed]
- Tahir, N.A.-R.; Azeez, H.A.; Muhammad, K.A.; Faqe, S.A.; Omer, D.A. Exploring of bioactive compounds in essential oil acquired from the stem and root derivatives of Hypericum triquetrifolium callus cultures. Nat. Prod. Res. 2019, 33, 1504–1508. [Google Scholar] [PubMed]
- Sha, A.M.; Garib, B.T. Antibacterial effect of curcumin against clinically isolated Porphyromonas gingivalis and connective tissue reactions to curcumin gel in the subcutaneous tissue of rats. BioMed Res. Int. 2019, 2019, 6810936. [Google Scholar]
- Ashimoto, A.; Chen, C.; Bakker, I.; Slots, J. Polymerase chain reaction detection of 8 putative periodontal pathogens in subgingival plaque of gingivitis and advanced periodontitis lesions. Oral Microbiol. Immunol. 1996, 11, 266–273. [Google Scholar]
- Lee, P.Y.; Costumbrado, J.; Hsu, C.-Y.; Kim, Y.H. Agarose gel electrophoresis for the separation of DNA fragments. JoVE (J. Vis. Exp.) 2012, 62, e3923. [Google Scholar]
- Lai, H.Y.; Lim, Y.Y.; Kim, K.H. Blechnum orientale Linn-a fern with potential as antioxidant, anticancer and antibacterial agent. BMC Complement. Altern. Med. 2010, 10, 53. [Google Scholar]
- Mith, H.; Dure, R.; Delcenserie, V.; Zhiri, A.; Daube, G.; Clinquart, A. Antimicrobial activities of commercial essential oils and their components against food-borne pathogens and food spoilage bacteria. Food Sci. Nutr. 2014, 2, 403–416. [Google Scholar]
- Mirpour, M.; Siahmazgi, Z.G.; Kiasaraie, M.S. Antibacterial activity of clove, gall nut methanolic and ethanolic extracts on Streptococcus mutans PTCC 1683 and Streptococcus salivarius PTCC 1448. J. Oral Biol. Craniofacial Res. 2015, 5, 7–10. [Google Scholar]
- Parvekar, P.; Palaskar, J.; Metgud, S.; Maria, R.; Dutta, S. The minimum inhibitory concentration (MIC) and minimum bactericidal concentration (MBC) of silver nanoparticles against Staphylococcus aureus. Biomater. Investig. Dent. 2020, 7, 105–109. [Google Scholar] [PubMed]
- Eladawy, M.; El-Mowafy, M.; El-Sokkary, M.M.A.; Barwa, R. Effects of lysozyme, proteinase K, and cephalosporins on biofilm formation by clinical isolates of Pseudomonas aeruginosa. Interdiscip. Perspect. Infect. Dis. 2020, 2020, 6156720. [Google Scholar]
- Sakaue, Y.; Takenaka, S.; Ohsumi, T.; Domon, H.; Terao, Y.; Noiri, Y. The effect of chlorhexidine on dental calculus formation: An in vitro study. BMC Oral Health 2018, 18, 52. [Google Scholar]
- Mittal, R.P.; Rana, A.; Jaitak, V. Essential oils: An impending substitute of synthetic antimicrobial agents to overcome antimicrobial resistance. Curr. Drug Targets 2019, 20, 605–624. [Google Scholar]
- Shayegh, S.; Rasooli, I.; Taghizadeh, M.; Alipoor Astaneh, S.D. Phytotherapeutic inhibition of supragingival dental plaque. Nat. Prod. Res. 2008, 22, 428–439. [Google Scholar]
- Gulati, R.K.; Bhatnagar, P.; Bhatnagar, A. Antimicrobial Efficacy of Chemical and Herbal Agents against Streptococcus mutans: An in vitro study. Pesqui. Bras. Em Odontopediatria E Clin. Integr. 2018, 18, 4008. [Google Scholar]
- Venkataraghavan, K.; Shah, S.; Choudhary, P.; Trivedi, K. Effectiveness of a new generation anti-cavity mouthwash on Streptococcus mutans and Lactobacillus acidophilus count: A microbiological study. World J. Dent. 2014, 5, 152–155. [Google Scholar]
- Sultan, S.; Telgi, C.R.; Chaudhary, S.; Manuja, N.; Kaur, H.; Amit, S.A.; Lingesha, R.T. Effect of ACP-CPP chewing gum and natural chewable products on plaque pH, calcium and phosphate concentration. J. Clin. Diagn. Res. JCDR 2016, 10, ZC13. [Google Scholar] [PubMed]
- Ghazi, M.; Goudarzi, H.; Ardekani, H.A.Z.; Habibi, M.; Azargashb, E.; Hajikhani, B.; Goudarzi, M. Investigation of Antibacterial Effect of Cuminum cyminum and Carum carvi against Streptococcus mutans and Streptococcus pyogenes. Nov. Biomed. 2019, 7, 30–34. [Google Scholar]
- Vignesh, S.; Anitha, R.; Kumar, S.R.; Lakshmi, T. Evaluation of the antimicrobial activity of cumin oil mediated silver nanoparticles on oral microbes. Res. J. Pharm. Technol. 2019, 12, 3709–3712. [Google Scholar]
- Araujo, R.O.; Souza, I.A.; Sena, K.; Brondani, D.J.; Solidônio, E.G. Avaliação biológica de Foeniculum vulgare (Mill.)(Umbelliferae/Apiaceae). Rev. Bras. Plantas Med. 2013, 15, 257–263. [Google Scholar] [CrossRef]
- Upadhyay, R.K. GC-MS analysis and in vitro antimicrobial susceptibility of Foeniculum vulgare seed essential oil. Am. J. Plant Sci. 2015, 6, 1058. [Google Scholar]
- Lemberkovics, E.; Kery, A.; Kakasy, A.; Szoke, E.; Simandi, B. Effect of extraction methods on the composition of essential oils. Acta Hortic. 2004, 597, 49–56. [Google Scholar] [CrossRef]
- Ale Omrani Nejad, S.M.H.; Naghdi Badi, H.; Mehrafarin, A.; Abdossi, V.; Khalighi-Sigaroodi, F. The Impact of Macro Environmental Factors on Essential Oils of Oliveria decumbens Vent. from Different Regions of Iran. Jundishapur J. Nat. Pharm. Prod. 2019, 14, e59456. [Google Scholar] [CrossRef]
- Singh, N.; Yadav, S.S.; Kumar, S.; Narashiman, B. A review on traditional uses, phytochemistry, pharmacology, and clinical research of dietary spice Cuminum cyminum L. Phytother. Res. 2021, 35, 5007–5030. [Google Scholar] [CrossRef] [PubMed]
- Allenspach, M.; Steuer, C. α-Pinene: A never-ending story. Phytochemistry 2021, 190, 112857. [Google Scholar] [CrossRef]
- Keskin, I.; Gunal, Y.; Ayla, S.; Kolbasi, B.; Sakul, A.; Kilic, U.; Gok, O.; Koroglu, K.; Ozbek, H. Effects of Foeniculum vulgare essential oil compounds, fenchone and limonene, on experimental wound healing. Biotech. Histochem. 2017, 92, 274–282. [Google Scholar] [CrossRef]
- Packiavathy, I.A.S.V.; Agilandeswari, P.; Musthafa, K.S.; Pandian, S.K.; Ravi, A.V. Antibiofilm and quorum sensing inhibitory potential of Cuminum cyminum and its secondary metabolite methyl eugenol against Gram negative bacterial pathogens. Food Res. Int. 2012, 45, 85–92. [Google Scholar]
- Di Napoli, M.; Castagliuolo, G.; Badalamenti, N.; Maresca, V.; Basile, A.; Bruno, M.; Varcamonti, M.; Zanfardino, A. Antimicrobial, Antibiofilm, and Antioxidant Properties of Essential Oil of Foeniculum vulgare Mill. Leaves. Plants 2022, 11, 3573. [Google Scholar] [CrossRef]
- Kwiatkowski, P.; Grygorcewicz, B.; Pruss, A.; Wojciuk, B.; Giedrys-Kalemba, S.; Dołêgowska, B.; Zielińska-Bliźniewska, H.; Olszewski, J.; Sienkiewicz, M.; Kochan, E. Synergistic effect of fennel essential oil and hydrogen peroxide on bacterial biofilm. Postep. Dermatol. Alergol. 2020, 37, 690–694. [Google Scholar] [CrossRef]
- Butera, A.; Pascadopoli, M.; Pellegrini, M.; Gallo, S.; Zampetti, P.; Scribante, A. Oral Microbiota in Patients with Peri-Implant Disease: A Narrative Review. Appl. Sci. 2022, 12, 3250. [Google Scholar]
- Vale, G.C.; Mayer, M.P.A. Effect of probiotic Lactobacillus rhamnosus by-products on gingival epithelial cells challenged with Porphyromonas gingivalis. Arch. Oral Biol. 2021, 128, 105174. [Google Scholar] [PubMed]
- Butera, A.; Pascadopoli, M.; Pellegrini, M.; Gallo, S.; Zampetti, P.; Cuggia, G.; Scribante, A. Domiciliary use of chlorhexidine vs. postbiotic gels in patients with peri-implant mucositis: A split-mouth randomized clinical trial. Appl. Sci. 2022, 12, 2800. [Google Scholar]

| Peak | Area% | Compound Name | CAS# | MW | MF |
|---|---|---|---|---|---|
| 1 | 1.17 | α-Pinene | 80-56-8 | 136.23 | C10H16 |
| 2 | 19.75 | β-Pinene | 127-91-3 | 136.23 | C10H16 |
| 3 | 0.53 | α-Phellandrene | 99-83-2 | 136.23 | C10H16 |
| 4 | 6.73 | 1,4-Diethylbenzene | 105-05-5 | 134.22 | C10H14 |
| 5 | 5.24 | O-Cymene | 934-80-5 | 134.22 | C10H14 |
| 6 | 20.08 | γ-Terpinene | 99-85-4 | 136.23 | C10H16 |
| 7 | 0.20 | cis-Limonene hydrate | 7299-41-4 | 186.33 | C12H26O |
| 8 | 0.31 | 2-Octen-4-ol | 4798-61-2 | 128.21 | C8H16O |
| 9 | 0.25 | Terpinen-4-ol | 562-74-3 | 154.25 | C10H18O |
| 10 | 2.01 | 10-Camphorsulfonyl chloride | 1000194-76-1 | 250.74 | C10H15ClO3S |
| 11 | 20.74 | Cumin aldehyde | 122-03-2 | 148.20 | C10H12O |
| 12 | 18.54 | 2-Caren-10-al | 151-85-9 | 150.22 | C10H14O |
| 13 | 0.20 | p-Mentha-1,4-dien-7-ol | 22539-72-6 | 152.23 | C10H16O |
| 14 | 0.22 | 3-Methyl-6-propyl-phenol | 31143-55-2 | 150.22 | C10H14O |
| 15 | 0.43 | β-Gurjunene | 17334-55-3 | 204.35 | C15H24 |
| 16 | 0.23 | Caryophyllene | 87-44-5 | 204.35 | C15H24 |
| 17 | 0.16 | alpha-Bergamotene | 17699-05-7 | 204.35 | C15H24 |
| 18 | 0.45 | cis-. beta. -Farnesene | 28973-97-9 | 204.35 | C15H24 |
| 19 | 0.44 | γ-Muurolene | 30021-74-0 | 204.35 | C15H24 |
| 20 | 0.24 | β-Bisabolene | 495-61-4 | 204.35 | C15H24 |
| 21 | 0.21 | Carotol | 465-28-1 | 222.37 | C15H26O |
| 22 | 0.29 | Methyl Palmitate | 112-39-0 | 270.45 | C17H34O2 |
| 23 | 019 | Palmitic acid | 57-10-3 | 256.42 | C16H32O2 |
| 24 | 0.15 | Methyl eladate | 1937-62-8 | 296.5 | C19H36O2 |
| 25 | 0.16 | Methyl stearate | 112-61-8 | 298.5 | C19H38O2 |
| 26 | 0.15 | Asclepic acid | 506-17-2 | 282.5 | C18H34O2 |
| 27 | 0.15 | Oleic acid | 112-80-1 | 282.5 | C18H34O2 |
| 28 | 0.76 | Clionasterol | 83-47-6 | 414.71 | C29H50O |
| Peak | Area% | Compound Name | CAS# | MW | MF |
|---|---|---|---|---|---|
| 1 | 1.23 | α-Pinene | 80-56-8 | 136.23 | C10H16 |
| 2 | 0.25 | β-Phellandrene | 555-10-2 | 136.23 | C10H16 |
| 3 | 0.45 | β-Myrcene | 123-35-3 | 136.23 | C10H16 |
| 4 | 13.92 | D-Limonene | 5989-27-5 | 136.23 | C10H16 |
| 5 | 0.39 | gamma-Terpinene | 99-85-4 | 136.23 | C10H16 |
| 6 | 10.32 | Fenchone | 1195-79-5 | 152.23 | C10H16O |
| 7 | 0.26 | Camphor | 76-22-2 | 152.23 | C10H16O |
| 8 | 0.18 | cis-Carveol | 1197-6-4 | 152.23 | C10H16O |
| 9 | 0.39 | Fenchyl acetate | 13851-11-1 | 196.29 | C12H20O2 |
| 10 | 0.71 | Cumin aldehyde | 122-03-2 | 148.20 | C10H12O |
| 11 | 1.22 | Anisaldehyde | 123-11-5 | 136.15 | C8H8O2 |
| 12 | 2.00 | Anethole | 104-46-1 | 148.20 | C10H12O |
| 13 | 67.16 | Estragole | 140-67-0 | 148.20 | C10H12O |
| 14 | 0.22 | Apiol | 523-80-8 | 222.24 | C12H14O4 |
| 15 | 0.64 | Palmitic acid, methyl ester | 112-39-0 | 270.45 | C17H34O2 |
| 16 | 0.27 | Elaidic acid, methyl ester | 1937-62-8 | 296.5 | C19H36O2 |
| 17 | 0.30 | Methyl stearate | 112-61-8 | 298.5 | C19H38O2 |
| EO % | Inhibition Zones (mm) (P. gingivalis) | Inhibition Zones (mm) (P. intermedia) | ||||
|---|---|---|---|---|---|---|
| EO | CHX 0.12% | p-Value | EO | CHX 0.12% | p-Value | |
| CEO 2.5% | 6.5 ± 0.27 | 14.2 ± 0.3 | 0.0001 | 10.5 ± 0.6 | 15.05 ± 0.39 | 0.001 |
| CEO 5% | 11.5 ± 0.27 | 14.1 ± 0.31 | 0.0001 | 12.9 ± 0.2 | 15.1 ± 0.4 | 0.023 |
| CEO 10% | 16.8 ± 0.4 | 14.05 ± 0.18 | 0.014 | 18.55 ± 0.35 | 15 ± 0.36 | 0.0001 |
| FEO 5% | 7.6 ± 0.39 | 14.4 ± 0.2 | 0.001 | 8.5 ± 0.55 | 15.3 ± 0.2 | 0.004 |
| FEO 10% | 8.9 ± 0.4 | 14.3 ± 0.5 | 0.001 | 9.4 ± 0.35 | 15.25 ± 0.3 | 0.004 |
| FEO 20% | 10.7 ± 0.4 | 14.45 ± 0.25 | 0.01 | 10.85 ± 0.4 | 15.3 ± 0.2 | 0.001 |
| Bacteria | CEO | FEO | ||
|---|---|---|---|---|
| MIC | MBC | MIC | MBC | |
| P. gingivalis | 3.125 µL/mL | 6.25 µL/mL | 3.125 µL/mL | 6.25 µL/mL |
| P. intermedia | 0.195 µL/mL | 0.195 µL/mL | 3.125 µL/mL | 3.125 µL/mL |
| Bacteria | CEO | FEO | CHX (0.12%) | MHB | ||
|---|---|---|---|---|---|---|
| 1st Tube | MIC Tube | 1st Tube | MIC Tube | |||
| P. gingivalis | 0 | ++ | + | ++ | 0 | +++ |
| P. intermedia | 0 | + | + | + | 0 | +++ |
Disclaimer/Publisher’s Note: The statements, opinions and data contained in all publications are solely those of the individual author(s) and contributor(s) and not of MDPI and/or the editor(s). MDPI and/or the editor(s) disclaim responsibility for any injury to people or property resulting from any ideas, methods, instructions or products referred to in the content. |
© 2023 by the authors. Licensee MDPI, Basel, Switzerland. This article is an open access article distributed under the terms and conditions of the Creative Commons Attribution (CC BY) license (https://creativecommons.org/licenses/by/4.0/).
Share and Cite
Rashid, A.H.; Gul, S.S.; Azeez, H.A.; Azeez, S.H. Extraction of Cuminum cyminum and Foeniculum vulgare Essential Oils and Their Antibacterial and Antibiofilm Activity against Clinically Isolated Porphyromonas gingivalis and Prevotella intermedia: An In Vitro Study. Appl. Sci. 2023, 13, 7996. https://doi.org/10.3390/app13147996
Rashid AH, Gul SS, Azeez HA, Azeez SH. Extraction of Cuminum cyminum and Foeniculum vulgare Essential Oils and Their Antibacterial and Antibiofilm Activity against Clinically Isolated Porphyromonas gingivalis and Prevotella intermedia: An In Vitro Study. Applied Sciences. 2023; 13(14):7996. https://doi.org/10.3390/app13147996
Chicago/Turabian StyleRashid, Ayub Hussein, Sarhang Sarwat Gul, Hoshyar Abdullah Azeez, and Shokhan Hamaali Azeez. 2023. "Extraction of Cuminum cyminum and Foeniculum vulgare Essential Oils and Their Antibacterial and Antibiofilm Activity against Clinically Isolated Porphyromonas gingivalis and Prevotella intermedia: An In Vitro Study" Applied Sciences 13, no. 14: 7996. https://doi.org/10.3390/app13147996
APA StyleRashid, A. H., Gul, S. S., Azeez, H. A., & Azeez, S. H. (2023). Extraction of Cuminum cyminum and Foeniculum vulgare Essential Oils and Their Antibacterial and Antibiofilm Activity against Clinically Isolated Porphyromonas gingivalis and Prevotella intermedia: An In Vitro Study. Applied Sciences, 13(14), 7996. https://doi.org/10.3390/app13147996

